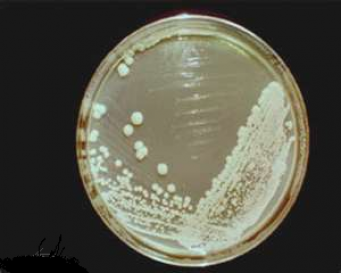

Yeast (Saccharomyces cerevisiae)
Products >> Consumables >> Microbiology >> Cultures >> Yeast (Saccharomyces cerevisiae)
Need More Information about Yeast (Saccharomyces cerevisiae)?
Question, comment or just feedback we want to know. Maybe you have question on what may compliment this product? We have the answers so ask the questions. We look forward to hearing from you.
Price: $24 + GST
Model Number: Y/SC
Saccharomyces cerevisiae cells are round to ovoid, 5–10 micrometres in diameter, and prefer to grow aerobically on glucose or maltose under acidic conditions. It is perhaps the most useful yeast, having been used in baking and brewing since ancient times. Saccharomyces cerevisiae is one of the most intensively studied eukaryotic model organisms in molecular and cell biology, much like Escherichia coli as the model bacterium. Many proteins important in human biology were first discovered by studying their homologs in yeast- proteins including cell cycle proteins, signalling proteins, and protein-processing enzymes.
